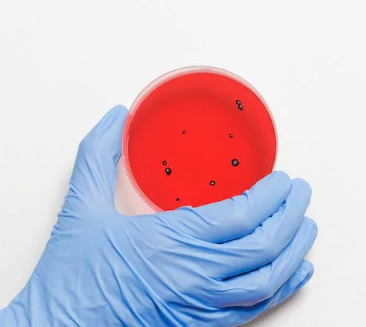
코로나 균들

코로나19로 가장 많은 피해를 입은 개인사업자와 소상공인들에게 한줄기의 희망이 되었던 새 출발기금 빠르게 예산소진으로 인해 신청하고 싶어도 할 수가 없었는데요..
이번 2024년 새해가 되면서 새출발기금 예산을 확보했다는 소식이 들려오네요~~

코로나 19로 피해를 입으신 개인사업자와 소상공인 분들은 예산 소진하기 전에 빠르게 아래에서 신청하시길 바랍니다.
새출발기금
새출발기금은 이번 코로나로 인해 피해를 입은 개인사업자와 소상공인이 보유하고 있는 금융권 대출에 대해 새 출발기금 신청을 하게되면 상환기간을 늘려줌과 동시에 금리부담을 낮추고 채무 상환이 어려운분들에게 원금조정이나 채무조정을 지원해주는 제도입니다.

새출발기금 지원대상
코로나 피해 (손실보전금 등 수령)를 입은 개인사업자 또는 법인 소상공인중 아래의 조건이 해당하시는 분
- 부실차주(3개월 이상 대출상환금을 연체한 차주)
- 부실우려차주(장기 연체에 빠질 위험이 있는 차주)
- 기타 코로나 19 피해사실을 객관적으로 증빙할 수 있는 차주(창구 방문 필요)

현재 대출이 있는 상태로 채무 조정을 원하시는 분들은 아래 조건에 해당되어야 합니다.
- 사업. 영업과 관련된 모든 사업자대출, 가계대출
- 최대 15억 원 (담보 10억 원+무담보 5억 원)
- *매입에 하자가 있거나 6개월 내 신규대출은 불가합니다.
새 출발기금 지원내용
- 대출상환기간조정
- 원금조정
- 금리조정
- 추심중단
- 강제집행중지
- 채무조정절차진행
새출발기금 신청방법
새출발기금을 바로 신청하실분들은 아래 링크를 통해 바로 신청하실수 있습니다.
새출발기금 신청한후에 신청일 다음달 15일까지 신청을 취소할수 있으며 그리고 고의 반복적인 채무조정 신청을 하시는 분들의 경우 신청 취소일로 부터 3개월간 재신청이 불가합니다.
새출발기금 신용변동 사항
새출발기금을 신청하게 되면 자신의 신용정보 변동내용이 궁금하실 텐데요.
부실차주의 경우 채무조정 프로그램 이용정보 등록으로 카드발급 제한 등의 불이익이 생길 수 있습니다.
2년간 정상 상환할 경우 위의 등록된 정보는 삭제가 되며 연체정보는 5년간 보존됩니다.
부실 우려 차주의 경우는 새 출발기금 신청으로 인해 불이익이 발생하지 않도록 제도를 개선할 계획이라고 합니다.
새출발기금 지원대출에서 제외되는 경우
- 중소벤처기업부 손실 보전금 지원대상 업종이 아닌 경우
- 코로나 피해와 무관하거나 매입요건상 하자등이 있는 경우
주의사항
새출발기금의 예산이 확보되면서 보이스피싱등도 아주 활개를 치고 있는데요.
대표 콜센터 전화번호는 1660-1378입니다.
위의 전화번호가 아닌 다른 번호로는 오는 연락은 보이스피싱일 수 있으니 각별히 주의하시길 바랍니다.
오늘은 새출발기금에 대해 자세히 알아보았습니다.
해당 사항이 되시는 분들은 꼭 신청하시길 바랍니다.
함께 읽으면 좋은 글
2023.12.26 - [대출] - 신불자 소액 대출 당일 비대면 승인 금리 알아보기
신불자 소액 대출 당일 비대면 승인 금리 알아보기
갑자기 급전이 필요하지만 현재 신용불량자라 대출할 곳이 없어서 불법 사금융 사채에 손을 벌리는 상황이 생길 수밖에 없는데요. 하지만 조금만 살펴본다면 신불자 소액 대출을 할 수 있는 곳
b.1yeol.com
2023.12.05 - [금융소식] - 신용회복위원회 채무조정 신청방법 조건확인
신용회복위원회 채무조정 신청방법 조건확인
코로나 시기를 거치면서 소상공인 자영업자뿐만 아니라 정말 많은 분들이 빚에 허덕이고 있는 것이 사실입니다. 오늘은 감당할수 없는 빚으로 인해 고통받는 분들을 위해 신용회복위원회 채무
b.1yeol.com
2023.11.13 - [대출] - 소액생계비 긴급대출 신청 예약 바로가기 (연체자, 무직자 가능)
소액생계비 긴급대출 신청 예약 바로가기 (연체자,무직자 가능)
대부업조차 대출을 해주지 않는 사람들은 급전이 필요할 때 막막하기만 한데요. 오늘은 대부업도 이용하기 어려운 분들에게 정부에서 재기의 발판을 마련해 드리기 위해 소액생계비 긴급대출
b.1yeol.com
2023.10.27 - [대출] - 케이뱅크 비상금대출 신청방법 최대 300만 원(조회 1분)
케이뱅크 비상금대출 신청방법 최대 300만원(조회 1분)
일전에 무직자 주부들도 이용이 가능한 카카오뱅크 비상금대출에 대해 상세히 알아보았는데요. 오늘은 케이뱅크에 급전이 필요할 때 자유롭게 이용할 수 있는 비상금대출에 대해 알아보려고
b.1yeol.com
'대출' 카테고리의 다른 글
| 무직자 정부지원 대출 가능한 곳 신청방법 (0) | 2024.02.03 |
|---|---|
| DSR 계산기 및 대출 가능 금액 (계산법 바로가기) (0) | 2024.01.18 |
| 신불자 소액 대출 당일 비대면 승인 금리 알아보기 (0) | 2023.12.26 |
| 대구은행 IM직장인 간편 신용대출 1억 8천만원까지 (0) | 2023.12.12 |
| 특례보금자리론 신청 방법 금리 자격 조건 알아보기 (0) | 2023.11.17 |